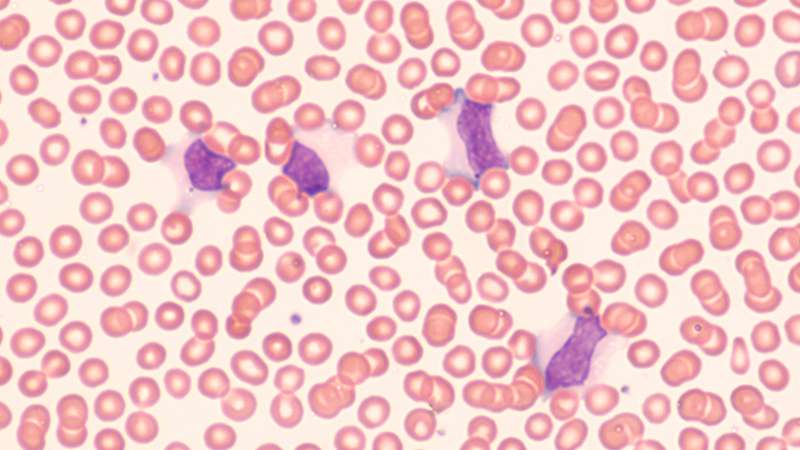
¿Qué enfermedad causa el virus de Epstein-Barr?

El virus de Epstein-Barr (EBV), también conocido como virus del herpes humano 4 (HHV-4), es uno de los virus más comunes en humanos, ya que infecta a más del 95% de la población adulta en todo el mundo. Esta alta prevalencia se debe a su capacidad para infectar células del sistema inmunitario, como los linfocitos B, y establecer una infección persistente de por vida en el hospedador.
Características generales del virus de Epstein-Barr
El virus de Epstein-Barr (EBV), también conocido como herpesvirus humano 4 (HHV-4), es un virus de la familia Herpesviridae con un genoma de ADN bicatenario de aproximadamente 172 kilobases. Posee una estructura envuelta con una cápside icosaédrica que contiene su material genético. Este virus presenta un tropismo predominante hacia los linfocitos B humanos, donde establece una infección latente de por vida. Además de los linfocitos B, puede infectar otros tipos celulares como células epiteliales, células T y células dendríticas.
El ciclo de vida del virus de Epstein-Barr comprende una fase de infección primaria, donde el virus infecta activamente los linfocitos B y se replica, seguida de una fase de latencia, durante la cual el virus persiste en el núcleo celular en forma episomal no integrada. Durante esta fase, el EBV puede permanecer inactivo o reactivarse bajo ciertas condiciones, dando lugar a la producción de viriones y la liberación de nuevas partículas virales.
El EBV es responsable de varias enfermedades en humanos, incluida la mononucleosis infecciosa, que se presenta con síntomas como fiebre, faringitis y fatiga. Además, el virus está asociado con el desarrollo de ciertos tipos de cáncer linfoproliferativo, como el linfoma de Burkitt, el carcinoma nasofaríngeo y ciertos linfomas en pacientes inmunocomprometidos, como aquellos con el virus de inmunodeficiencia humana (VIH).
La interacción entre el virus de Epstein-Barr y el sistema inmunitario del hospedador es crucial en la patogenia de las enfermedades asociadas con este virus. El entendimiento de las características microbiológicas del EBV, incluidas su estructura, ciclo de vida, tropismo celular y patogenia, es esencial para el desarrollo de estrategias diagnósticas, preventivas y terapéuticas eficaces para las enfermedades asociadas con este virus.
Características generales de la mononucleosis infecciosa
La principal manifestación clínica asociada con la infección primaria por el virus de Epstein-Barr es la mononucleosis infecciosa, una enfermedad caracterizada por síntomas como fiebre, faringitis, inflamación de los ganglios linfáticos, fatiga extrema y aumento del número de glóbulos blancos atípicos en la sangre (linfocitos atípicos). La mononucleosis infecciosa suele presentarse en adolescentes y adultos jóvenes, pero también puede ocurrir en niños e incluso en adultos mayores.
La infección por EBV se transmite principalmente a través de la saliva, por lo que se la conoce comúnmente como la «enfermedad del beso». Después de la infección inicial, el virus permanece latente en los linfocitos B y puede reactivarse periódicamente a lo largo de la vida del individuo, aunque en la mayoría de los casos no causa síntomas significativos. Sin embargo, en personas con sistemas inmunitarios comprometidos, como aquellos con inmunodeficiencias o trasplantes de órganos, la reactivación del EBV puede dar lugar a enfermedades más graves, como linfomas y carcinomas asociados al virus.
La mononucleosis infecciosa suele ser autolimitada y la mayoría de los pacientes se recuperan completamente con reposo y tratamiento sintomático. Sin embargo, en algunos casos, pueden desarrollarse complicaciones como agrandamiento del bazo, anemia hemolítica y, en casos raros, complicaciones neurológicas.


